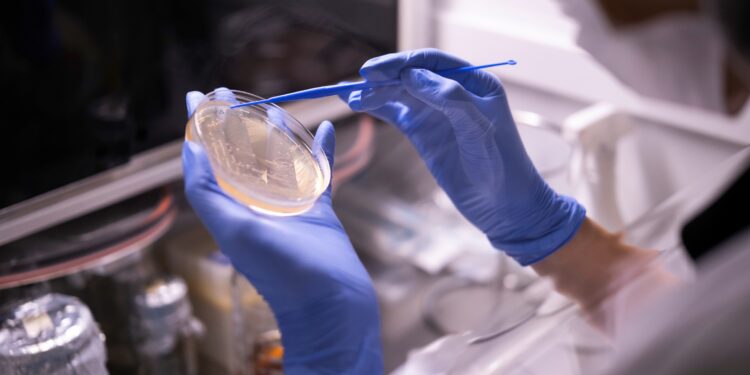
Nuvita İlaç, Ar-Ge yatırımlarıyla Türkiye’nin ilk 250 şirketi arasında

Orzaks’ın üretim faaliyetlerini üstlenen stratejik üretim merkezi Nuvita İlaç, Türkiye’nin en fazla Ar-Ge yatırımı yapan ilk 250 firma arasına girdi. Ekonomi ve iş dünyası portalı Turkishtime tarafından hazırlanan “Türkiye Ar-Ge 250 Araştırması 2024” sonuçlarına göre Nuvita İlaç, geçen yıl yer aldığı ilk 500 şirket listesinden bu yıl performansını artırarak ilk 250’ye yükseldi.
Ar-Ge yatırımlarında istikrarlı büyüme
Uluslararası standartlara uygun üretim yaklaşımı ve bilime dayalı Ar-Ge faaliyetleriyle öne çıkan Nuvita İlaç, 2021’den bu yana Ar-Ge harcamalarını 10 kat artırdı. Toplamda 100 milyon TL’yi aşan yatırımlarıyla inovasyona güçlü bir destek veren şirketin Ar-Ge Merkezi’nde bugün itibarıyla 38 proje yürütülüyor. Bugüne kadar 9 kamu projesini tamamlayan Nuvita İlaç, 2 kamu projesi üzerinde geliştirme çalışmalarını sürdürüyor. Ayrıca 2023’te 2, 2024’te 9 olmak üzere toplam 11 patent başvurusu da bulunuyor.
“Bilimsel bilgiyi ekonomik değere dönüştürüyoruz”
Nuvita İlaç Ar-Ge Müdürü Akif Kavak, araştırma sonuçlarına ilişkin yaptığı değerlendirmede şunları söyledi:
“Ar-Ge ve inovasyona yaptığımız yatırımlar, yalnızca şirketimizin büyümesini değil, aynı zamanda ülkemizin kalkınma hedeflerini de destekliyor. Bilimsel bilginin ekonomik değere dönüşmesini sağlayarak hem akademiye hem de özel sektöre katkı sunuyoruz. Özellikle stratejik hammaddelerin üretimine yönelik çalışmalarımızla ülkemizin ihtiyacına cevap verirken, insan sağlığına değer katacak yenilikçi çözümler geliştirmeye devam edeceğiz.”
İnovasyon odaklı üretim
Orzaks’ın üretim gücü olan Nuvita İlaç, Ar-Ge merkezinde yürüttüğü inovatif projeler, patent başvuruları ve stratejik yatırımlarıyla sağlık sektöründe sürdürülebilir büyümenin öncülerinden biri olmayı sürdürüyor.